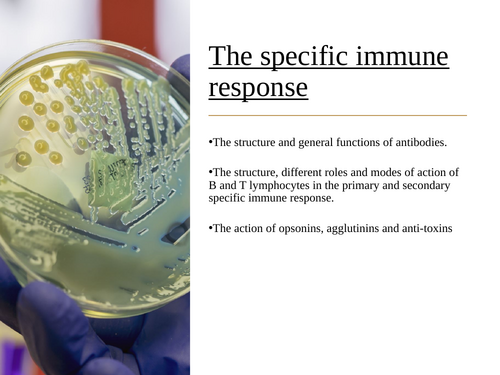
pptx, 802.83 KB

This is an up to date version of the new OCR A (A-Level) course. I have carefully crafted these PowerPoints over ten years - you will not need to create another Powerpoint again (New for 2026-27). MY TOP SELLING RESOURCE!
NOW IN CHAPTER ORDER!
Includes all PowerPoints with assessment questions throughout.
Every lesson starts with a knowledge retrieval recap and answers are includes on the majority of slides for you!
All stats tests and PAGS included.
All answers are provided and animated onto the PPt ready to appear when you wish.
Stop paying £5+ for one unit - you have the whole course here! Enjoy and please leave a review!
Get this resource as part of a bundle and save up to 20%
A bundle is a package of resources grouped together to teach a particular topic, or a series of lessons, in one place.
Something went wrong, please try again later.
Wonderful resource! Best out there and a very good price! Very teacher friendly and having all the answers provided is amazing!
Thanks for the update. It is now much easier for new teachers to this course to have a great bank of resources to follow.
Hi, Thank you for sharing your resources. I am new to teaching the OCR specification. In the bundle, there is a PDF file titled topic on a page. I am unable to open this, as it required a code. Additionally, does your bundle include classification?
Thankyou!
Fantastic! Far better than anything I’ve found on Tes - covers the whole course and brilliant assessment with answers throughout - recommend 👍
Report this resourceto let us know if it violates our terms and conditions.
Our customer service team will review your report and will be in touch.